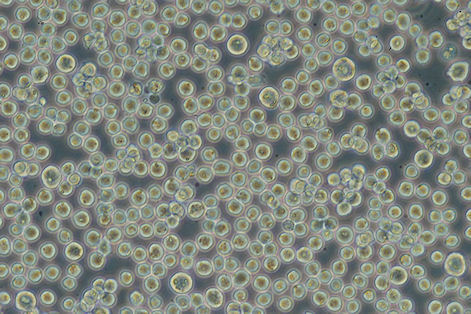

ID |
TKG 0478 |
Cell name |
L1210 TGR4 |
Data accepted |
April, 1996. |
Animal |
DBA/2 mouse. |
Scientific name |
Mus musculus. |
Sex |
|
Case history |
|
Tissue |
Leukemia. |
Genetics |
|
Life span |
Infinite. |
Morphology |
Lymphoblastic. |
Medium |
RPMI-1640 + 10% FBS, 10 μg 6TG/ml). |
Passage method |
Dilute 1/4 every 3-4 days. |
Characteristics |
This line was selected by the treatment of EMS from L1210. Resistant to 6TG (10
microgram/ml). This line is more immunogenic than the parent line and incapable
of forming ascites tumors in BDF1 mice. 86 KDa (p86) protein, specific to this
line, was identified as tumor rejection antigen by the studies of cell fusion
between L1210 TGR4 and parent line. Immune-response directed to the specific p86
on L1210 TGR4 may be involved in the loss of tumorigenicity of this line. |
CO2 concentration |
5% |
Subculture frequency |
|
Classification |
|
Mycoplasma |
PCR: -, Hoechst DNA staining: - |
Isozyme analysis |
LD |
Established by |
Noriko Yamada (1st. Biochem. Kanazawa Medical Univ. Uchinada, Ishikawa). |
References |
4st Int. Congress of Cell Biol. Aug. 1988. Abstract, p46. |
References by users |
|
Comments |
|
Deposited by |
Noriko Yamada |
Restriction |
|
Photo |
|